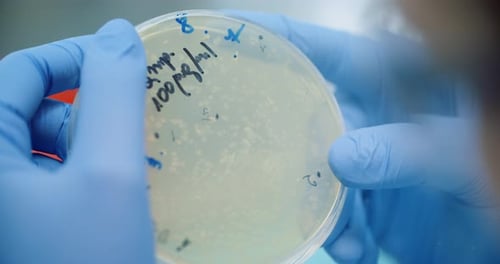
Hands Examine Petri Dish with Cell Colonies
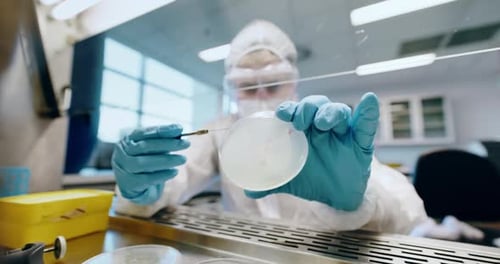
Lab Technician Working with Petri Dish in Laboratory

Scientist Working with Sample in Laboratory
By DragonImagesOne great value subscription from $16.50/month
- Unlimited downloads of 27+ million creative assets
- AI Tools: video, image and more
- Lifetime commercial license
- Easy cancellation
Already have an account? Sign in
Attributes
- Length
- 0:11
- Resolution
- 3840 x 2160
- File Size
- 526 MB
- Frame Rate
- 25 fps
- Alpha Channel
- No
- Looped
- No
- Video Encoding
- ProRes
- Orientation
- Horizontal
- Commercial License
- Further Information
Description
Close up shot of a scientist in a lab coat and blue gloves using a small tool to adjust a sample in a petri dish next to a microscope. The scene is well lit. This footage could be used for videos about science, laboratory research, and medical developments.
All
Music
Sound Effects